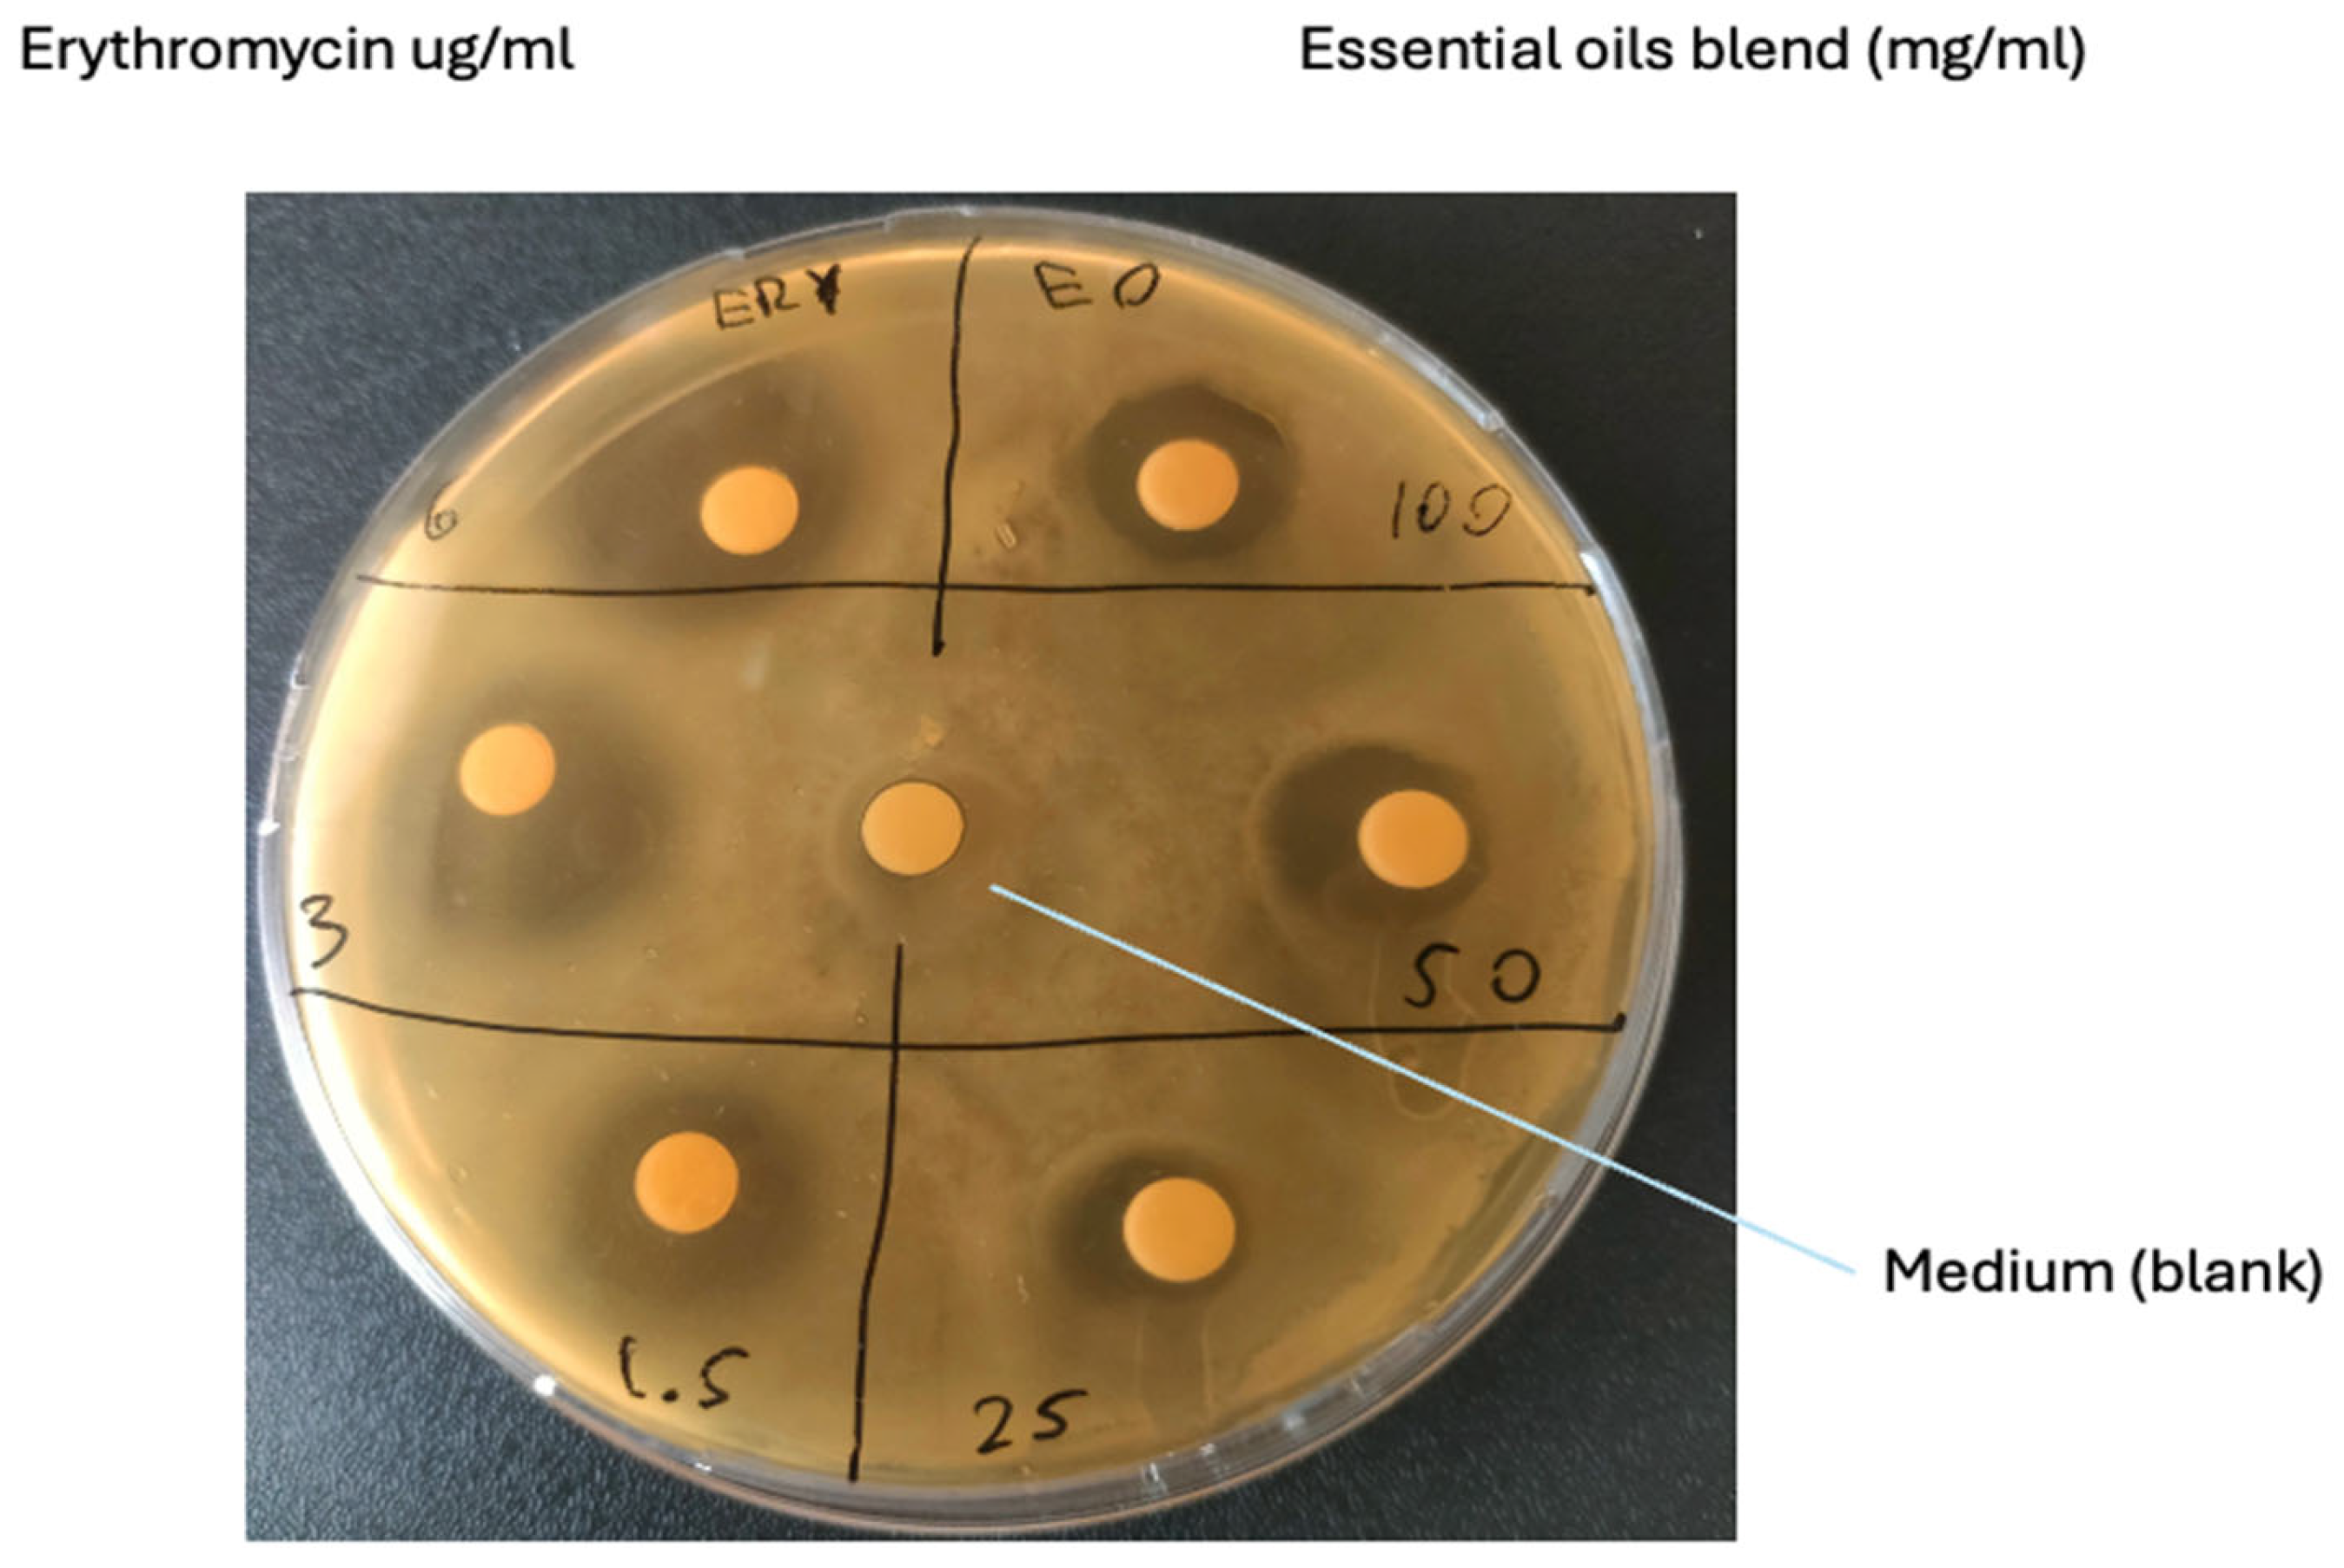
Vetsci 12 00659 g001

Mitigating Bovine Mastitis and Raw Milk Pathogen Risks: Inhibition of Staphylococcus xylosus by Mediterranean Plants’ Essential Oil
Simple Summary
Abstract
1. Introduction
2. Materials and Methods
2.1. Sample Collection
2.2. Bacterial Isolation
2.3. Bacterial Identification
2.4. Susceptibility Testing
2.5. Minimum Bactericidal Concentration (MBC) and Minimum Inhibitory Concentration (MIC) Evaluation
3. Results
3.1. Bacterial Pathogen Isolation and Identification
3.2. Susceptibility Testing
3.3. MBC and MIC Evaluation
4. Discussion
5. Conclusions
Supplementary Materials
Author Contributions
Funding
Institutional Review Board Statement
Informed Consent Statement
Data Availability Statement
Conflicts of Interest
References
- Piras, C.; De Fazio, R.; Di Francesco, A.; Oppedisano, F.; Spina, A.A.; Cunsolo, V.; Roncada, P.; Cramer, R.; Britti, D. Detection of antimicrobial proteins/peptides and bacterial proteins involved in antimicrobial resistance in raw cow’s milk from different breeds. Antibiotics 2024, 13, 838. [Google Scholar] [CrossRef]
- Lin, T.; Meletharayil, G.; Kapoor, R.; Abbaspourrad, A. Bioactives in bovine milk: Chemistry, technology, and applications. Nutr. Rev. 2021, 79, 48–69. [Google Scholar] [CrossRef] [PubMed]
- Quigley, L.; O’Sullivan, O.; Stanton, C.; Beresford, T.P.; Ross, R.P.; Fitzgerald, G.F.; Cotter, P.D. The complex microbiota of raw milk. FEMS Microbiol. Rev. 2013, 37, 664–698. [Google Scholar] [CrossRef] [PubMed]
- Necidova, L.; Bogdanovicova, K.; Harustiakova, D.; Bartova, K. Short communication: Pasteurization as a means of inactivating staphylococcal enterotoxins A, B, and C in milk. J. Dairy Sci. 2016, 99, 8638–8643. [Google Scholar] [CrossRef] [PubMed]
- Rosengren, Å.; Fabricius, A.; Guss, B.; Sylvén, S.; Lindqvist, R. Occurrence of foodborne pathogens and characterization of Staphylococcus aureus in cheese produced on farm-dairies. Int. J. Food Microbiol. 2010, 144, 263–269. [Google Scholar] [CrossRef]
- Hassan, A.N.; Frank, J.F. Microorganisms Associated with Milk. In Encyclopedia of Dairy Sciences, 2nd ed.; Fuquay, J.W., Ed.; Academic Press: San Diego, CA, USA, 2011; pp. 447–457. ISBN 978-0-12-374407-4. [Google Scholar]
- Bochniarz, M.; Wawron, W.; Szczubial, M.; Brodzki, P.; Piech, T.; Kusy, R. Characteristics of Staphylococcus xylosus isolated from subclinical mastitis in cows. Ann. Anim. Sci. 2014, 14, 859. [Google Scholar] [CrossRef]
- Yoon, Y.; Lee, S.; Choi, K.H. Microbial benefits and risks of raw milk cheese. Food Control 2016, 63, 201–215. [Google Scholar] [CrossRef]
- Lahou, E.; Uyttendaele, M. Growth potential of Listeria monocytogenes in soft, semi-soft and semi-hard artisanal cheeses after post-processing contamination in deli retail establishments. Food Control 2017, 76, 13–23. [Google Scholar] [CrossRef]
- Piras, C.; Greco, V.; Gugliandolo, E.; Soggiu, A.; Tilocca, B.; Bonizzi, L.; Zecconi, A.; Cramer, R.; Britti, D.; Urbani, A.; et al. Raw cow milk bacterial consortium as bioindicator of circulating anti-microbial resistance (Amr). Animals 2020, 10, 2378. [Google Scholar] [CrossRef]
- Leroy, S.; Lebert, I.; Andant, C.; Talon, R. Interaction in dual species biofilms between Staphylococcus xylosus and Staphylococcus aureus. Int. J. Food Microbiol. 2020, 326, 108653. [Google Scholar] [CrossRef]
- Mielcarek, N.; Alonso, S.; Locht, C. Nasal vaccination using live bacterial vectors. Adv. Drug Deliv. Rev. 2001, 51, 55–69. [Google Scholar] [CrossRef] [PubMed]
- Hou, T.; Sana, S.S.; Li, H.; Xing, Y.; Nanda, A.; Netala, V.R.; Zhang, Z. Essential oils and its antibacterial, antifungal and anti-oxidant activity applications: A review. Food Biosci. 2022, 47, 101716. [Google Scholar] [CrossRef]
- Uner, B.; Guler, E.; Vicir, M.E.; Kayhan, H.; Atsu, N.; Kalaskar, D.; Cam, M.E. Antiviral properties of essential oil mixture: Modulation of E7 and E2 protein pathways in human papillomavirus (HPV) infection. J. Ethnopharmacol. 2025, 341, 119289. [Google Scholar] [CrossRef] [PubMed]
- Oppedisano, F.; De Fazio, R.; Gugliandolo, E.; Crupi, R.; Palma, E.; Abbas Raza, S.H.; Tilocca, B.; Merola, C.; Piras, C.; Britti, D. Mediterranean Plants with Antimicrobial Activity against Staphylococcus aureus, a Meta-Analysis for Green Veterinary Pharmacology Applications. Microorganisms 2023, 11, 2264. [Google Scholar] [CrossRef]
- Rapper, S.L.D.; Viljoen, A.; van Vuuren, S. Essential oil blends: The potential of combined use for respiratory tract infections. Antibiotics 2021, 10, 1517. [Google Scholar] [CrossRef]
- Jahja, E.J.; Yuliana, R.; Simanjuntak, W.T.; Fitriya, N.; Rahmawati, A.; Yulinah, E. Potency of Origanum vulgare and Andrographis paniculata extracts on growth performance in poultry. Vet. Anim. Sci. 2023, 19, 100274. [Google Scholar] [CrossRef]
- Piras, C.; Hale, O.; Reynolds, C.K.; Jones, B.; Taylor, N.; Morris, M.; Cramer, R. LAP-MALDI MS coupled with machine learning: An ambient mass spectrometry approach for high-throughput diagnostics. Chem. Sci. 2022, 13, 1746–1758. [Google Scholar] [CrossRef]
- Piras, C.; Tilocca, B.; Castagna, F.; Roncada, P.; Britti, D.; Palma, E. Plants with Antimicrobial Activity Growing in Italy: A Pathogen-Driven Systematic Review for Green Veterinary Pharmacology Applications. Antibiotics 2022, 11, 919. [Google Scholar] [CrossRef]
- Zheng, S.; Zhang, Z.; Ma, J.; Qu, Q.; God’spowe, B.; Qin, Y.; Chen, X.; Li, L.U.; Zhou, D.; Ding, W. CD-g-CS nanoparticles for enhanced antibiotic treatment of Staphylococcus xylosus infection. Microb. Biotechnol. 2022, 15, 535–547. [Google Scholar] [CrossRef]
- Mohammed, H.A.; Sulaiman, G.M.; Khan, R.A.; Al-Saffar, A.Z.; Mohsin, M.H.; Albukhaty, S.; Ismail, A. Essential oils pharmacological activity: Chemical markers, biogenesis, plant sources, and commercial products. Process Biochem. 2024, 144, 112–132. [Google Scholar] [CrossRef]
- de Sousa, D.P.; Damasceno, R.O.S.; Amorati, R.; Elshabrawy, H.A.; de Castro, R.D.; Bezerra, D.P.; Nunes, V.R.V.; Gomes, R.C.; Lima, T.C. Essential oils: Chemistry and pharmacological activities. Biomolecules 2023, 13, 1144. [Google Scholar] [CrossRef] [PubMed]
- Honkanen-Buzalski, T.; Myllys, V.; Pyörälä, S. Bovine clinical mastitis due to coagulase-negative staphylococci and their susceptibility to antimicrobials. J. Vet. Med. Ser. B 1994, 41, 344–350. [Google Scholar] [CrossRef] [PubMed]
- Myllys, V.; Asplund, K.; Brofeldt, E.; Hirvelä-Koski, V.; Honkanen-Buzalski, T.; Junttila, J.; Kulkas, L.; Myllykangas, O.; Niskanen, M.; Saloniemi, H. Bovine mastitis in Finland in 1988 and 1995-changes in prevalence and antimicrobial resistance. Acta Vet. Scand. 1998, 39, 119. [Google Scholar] [CrossRef] [PubMed]
- Malinowski, E.; Lassa, H.; Kłlossowska, A.; Smulski, S.; Markiewicz, H.; Kaczmarowski, M. Etiological agents of dairy cows’ mastitis in western part of Poland. Pol. J. Vet. Sci. 2006, 9, 191–194. [Google Scholar]
- Taponen, S.; Simojoki, H.; Haveri, M.; Larsen, H.D.; Pyörälä, S. Clinical characteristics and persistence of bovine mastitis caused by different species of coagulase-negative staphylococci identified with API or AFLP. Vet. Microbiol. 2006, 115, 199–207. [Google Scholar] [CrossRef]
- Waller, K.P.; Aspán, A.; Nyman, A.; Persson, Y.; Andersson, U.G. CNS species and antimicrobial resistance in clinical and subclinical bovine mastitis. Vet. Microbiol. 2011, 152, 112–116. [Google Scholar] [CrossRef]
- Bochniarz, M.; Wawron, W.; Szczubial, M. Coagulase-negative staphylococci (CNS) as an aetiological factor of mastitis in cows. Pol. J. Vet. Sci. 2013, 16, 487–492. [Google Scholar] [CrossRef]
- Coelho, M.C.; Malcata, F.X.; Silva, C.C.G. Lactic acid bacteria in raw-milk cheeses: From starter cultures to probiotic functions. Foods 2022, 11, 2276. [Google Scholar] [CrossRef]
- Wiśniewski, P.; Gajewska, J.; Zadernowska, A.; Chajęcka-Wierzchowska, W. Identification of the Enterotoxigenic Potential of Staphylococcus spp. from Raw Milk and Raw Milk Cheeses. Toxins 2023, 16, 17. [Google Scholar] [CrossRef]
- Ruaro, A.; Andrighetto, C.; Torriani, S.; Lombardi, A. Biodiversity and characterization of indigenous coagulase-negative staphylococci isolated from raw milk and cheese of North Italy. Food Microbiol. 2013, 34, 106–111. [Google Scholar] [CrossRef]
- Reshamwala, K.; Cheung, G.Y.C.; Hsieh, R.C.; Liu, R.; Joo, H.-S.; Zheng, Y.; Bae, J.S.; Nguyen, T.H.; Villaruz, A.E.; Gozalo, A.S. Identification and characterization of the pathogenic potential of phenol-soluble modulin toxins in the mouse commensal Staphylococcus xylosus. Front. Immunol. 2022, 13, 999201. [Google Scholar] [CrossRef] [PubMed]
- Addis, E.; Fleet, G.H.; Cox, J.M.; Kolak, D.; Leung, T. The growth, properties and interactions of yeasts and bacteria associated with the maturation of Camembert and blue-veined cheeses. Int. J. Food Microbiol. 2001, 69, 25–36. [Google Scholar] [CrossRef] [PubMed]
- Wipf, J.R.K.; Schwendener, S.; Perreten, V. The novel macrolide-lincosamide-streptogramin B resistance gene erm (44) is associated with a prophage in Staphylococcus xylosus. Antimicrob. Agents Chemother. 2014, 58, 6133–6138. [Google Scholar] [CrossRef] [PubMed]
- Chouhan, S.; Sharma, K.; Guleria, S. Antimicrobial activity of some essential oils—Present status and future perspectives. Medicines 2017, 4, 58. [Google Scholar] [CrossRef]

| Sample ID | Best Match | Score Value | Second-Best Match | Score Value |
|---|---|---|---|---|
| cow 1a | Staphylococcus xylosus | 2.13 | Staphylococcus xylosus | 2.05 |
| cow 1c | Staphylococcus xylosus | 1.87 | Staphylococcus xylosus | 1.81 |
| cow 2a | Staphylococcus xylosus | 2.05 | Staphylococcus xylosus | 1.98 |
| cow 2b | Staphylococcus xylosus | 2.19 | Staphylococcus xylosus | 2.19 |
| cow 2c | Staphylococcus xylosus | 2.07 | Staphylococcus xylosus | 1.83 |
| Treatment | Average Inhibition Zone (Diameter; mm-SD) | Zone Diameter Interpretative Standards for Staphylococcus Species (mm) * | Antibiotic Susceptibility Results |
|---|---|---|---|
| Ethanol (medium) | 6-0 | No inhibition | |
| EO Blend 100 mg/mL | 13.33-1.15 | Sensible | |
| EO Blend 50 mg/mL | 15.33-9.40 | Sensible | |
| EO Blend 25 mg/mL | 9-1 | Sensible | |
| Erythromycin 6 µg/mL | 23-4.59 | ≥5.2 | Sensible |
| Erythromycin 3 µg/mL | 18.6-3.51 | ≥2.6 | Sensible |
| Erythromycin 1.5 µg/mL | 15.33-3.05 | ≥1.3 | Sensible |
| Treatment | Minimum Inhibitory Concentration % |
|---|---|
| Cistus ladanifer | 1–0.5 |
| Mirtus communis | 0.5–0.25 |
| Salvia officinalis | 0.5–0.25 |
| essential oil blend | 0.5–0.25 |
| Erythromycin | <0.1 µg/mL |
Disclaimer/Publisher’s Note: The statements, opinions and data contained in all publications are solely those of the individual author(s) and contributor(s) and not of MDPI and/or the editor(s). MDPI and/or the editor(s) disclaim responsibility for any injury to people or property resulting from any ideas, methods, instructions or products referred to in the content. |
© 2025 by the authors. Licensee MDPI, Basel, Switzerland. This article is an open access article distributed under the terms and conditions of the Creative Commons Attribution (CC BY) license (https://creativecommons.org/licenses/by/4.0/).
Share and Cite
De Fazio, R.; Di Giacinto, G.; Roncada, P.; Britti, D.; Odore, R.; Badino, P.; Piras, C. Mitigating Bovine Mastitis and Raw Milk Pathogen Risks: Inhibition of Staphylococcus xylosus by Mediterranean Plants’ Essential Oil. Vet. Sci. 2025, 12, 659. https://doi.org/10.3390/vetsci12070659
De Fazio R, Di Giacinto G, Roncada P, Britti D, Odore R, Badino P, Piras C. Mitigating Bovine Mastitis and Raw Milk Pathogen Risks: Inhibition of Staphylococcus xylosus by Mediterranean Plants’ Essential Oil. Veterinary Sciences. 2025; 12(7):659. https://doi.org/10.3390/vetsci12070659
Chicago/Turabian StyleDe Fazio, Rosario, Giacomo Di Giacinto, Paola Roncada, Domenico Britti, Rosangela Odore, Paola Badino, and Cristian Piras. 2025. "Mitigating Bovine Mastitis and Raw Milk Pathogen Risks: Inhibition of Staphylococcus xylosus by Mediterranean Plants’ Essential Oil" Veterinary Sciences 12, no. 7: 659. https://doi.org/10.3390/vetsci12070659
APA StyleDe Fazio, R., Di Giacinto, G., Roncada, P., Britti, D., Odore, R., Badino, P., & Piras, C. (2025). Mitigating Bovine Mastitis and Raw Milk Pathogen Risks: Inhibition of Staphylococcus xylosus by Mediterranean Plants’ Essential Oil. Veterinary Sciences, 12(7), 659. https://doi.org/10.3390/vetsci12070659

